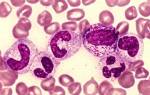

Что такое токсическая зернистость нейтрофилов
Существует ряд изменений в нейтрофилах, которые не всегда связаны с токсикозом у человека. Токсигенная зернистость нейтрофилов получила свое название, поскольку впервые была выявлена у пациентов с сепсисом, вызванным грамотрицательными бактериями. Однако это не означает, что такие микроорганизмы оказывают токсическое воздействие на данные элементы крови.
Когда речь идет о данном состоянии, обычно подразумевается специфическое нарушение морфологического строения клеток, возникающее в условиях активной стимуляции их образования в костном мозге и ускоренного созревания. Это отражает асинхронные процессы созревания ядра и цитоплазмы клеток крови.
Указанная патология лейкоцитов проявляется тем, что в цитоплазме образуются крупные гранулы и специфические вкрапления. Это происходит из-за изменений в структуре белков данной части клетки. Также возможно образование специфических телец Деле и цитоплазматических вакуолей.
Токсическая зернистость нейтрофилов представляет собой морфологическое изменение, которое наблюдается при различных патологических состояниях, таких как инфекции, воспаления и интоксикации. Врачи отмечают, что это явление связано с нарушением созревания нейтрофилов в костном мозге, что приводит к образованию аномальных гранул в цитоплазме клеток. Эти изменения могут служить маркерами активного воспалительного процесса и указывать на тяжесть состояния пациента. Специалисты подчеркивают, что токсическая зернистость не является самостоятельным диагнозом, а лишь отражает реакцию организма на стрессовые факторы. Важно учитывать это изменение в контексте клинической картины, чтобы правильно интерпретировать результаты анализов и назначить адекватное лечение.

Причины нарушений клеток
Токсическая зернистость нейтрофилов может возникать по следующим причинам:
- Воспалительные процессы гнойного характера в организме.
- Заболевания, приводящие к ухудшению общего состояния пациента.
- Онкологические образования, находящиеся на стадии распада.
- Воздействие радиационного излучения на организм.
Кроме того, изменения в нейтрофилах могут быть связаны с такими состояниями, как:
- крупозная пневмония;
- перитонит;
- флегмона;
- образование рассасывающегося инфильтрата.
| Признак токсической зернистости нейтрофилов | Описание | Клиническое значение |
|---|---|---|
| Токсичная зернистость | Крупные, темно-фиолетовые или сине-черные гранулы в цитоплазме нейтрофилов, видимые при окрашивании по Романовскому-Гимзе. | Указывает на тяжелую инфекцию, воспаление или сепсис. |
| Тельца Деле (базофильная цитоплазматическая инклюзия) | Крупные, овальные или круглые базофильные включения в цитоплазме нейтрофилов. | Показатель тяжелого повреждения костного мозга, инфекции или воспаления. |
| Вакуолизация цитоплазмы | Наличие вакуолей (пустот) в цитоплазме нейтрофилов. | Может указывать на тяжелую инфекцию, сепсис или недостаточность функции костного мозга. |
| Увеличение количества сегментоядерных нейтрофилов | Повышенное количество сегментированных нейтрофилов в периферической крови. | Может быть признаком инфекции или воспаления, но само по себе не является специфическим показателем токсической зернистости. |
| Сдвиг влево | Повышенное количество молодых форм нейтрофилов (палочкоядерных и метамиелоцитов) в периферической крови. | Указывает на усиленный лейкопоэз в ответ на инфекцию или воспаление, часто сопровождает токсическую зернистость. |
Токсическая зернистость у малышей
Токсическая зернистость нейтрофилов у детей может возникать, если они перенесли инфекцию (или сразу после выздоровления), которая была связана с высокой температурой, длительной лихорадкой и обильным выделением гноя. К таким заболеваниям относятся:
- корь или скарлатина;
- острые заболевания органов брюшной полости, начавшиеся внезапно;
- все состояния, относящиеся к категории «острый живот»;
- кожные заболевания, сопровождающиеся выраженным гнойным процессом (например, флегмона).
Иногда подобное состояние у детей может быть связано с болезнью Чедиака-Хигаси. Это крайне редкое и наследственное заболевание, при котором поражаются все клетки лейкоцитарного ряда, что приводит к значительной недостаточности иммунной системы.
Дети с этой патологией часто сталкиваются с рецидивирующими инфекциями и гнойничковыми заболеваниями. Кроме того, у них наблюдается повышенная предрасположенность к геморрагиям, которые могут иметь злокачественное течение. К сожалению, прогноз для таких пациентов зачастую оказывается неблагоприятным.
Токсическая зернистость нейтрофилов — это явление, которое вызывает интерес и обсуждение среди медицинских специалистов и пациентов. Многие отмечают, что это может быть признаком различных заболеваний, таких как инфекции, воспалительные процессы или даже некоторые виды рака. Врачам важно правильно интерпретировать результаты анализов, так как токсическая зернистость может указывать на активную реакцию организма на патогены.
Некоторые пациенты, узнав о наличии токсической зернистости, начинают беспокоиться, не понимая, что это не всегда свидетельствует о серьезной патологии. Важно помнить, что это лишь один из маркеров, который должен рассматриваться в контексте других клинических данных. Обсуждая эту тему, люди часто подчеркивают необходимость комплексного подхода к диагностике и лечению, а также важность консультаций с квалифицированными специалистами.

Токсическая зернистость во время беременности
Во время беременности могут наблюдаться небольшие изменения в структуре лейкоцитов. Обычно такие изменения не представляют угрозы для здоровья. Это состояние считается нормальным, если женщина не испытывает дискомфорта или других негативных симптомов.
Как правило, при обследовании беременных в подобных ситуациях не выявляется никаких отклонений, если остальные показатели крови находятся в пределах нормы.
Показатели нормы структуры клеток
Какова же норма токсической зернистости? Обычный уровень составляет 0%. Тем не менее, существуют определенные условия, при которых незначительное увеличение аномальных клеток может потребовать наблюдения со стороны врача. К таким ситуациям относятся:
- послеоперационный период;
- восстановление после инфекционного заболевания;
- беременность.
Важно помнить, что любое превышение нормальных показателей свидетельствует о наличии патологических процессов в организме. Во время лечения врач осуществляет мониторинг количества аномальных клеток, чтобы оценить эффективность терапии и при необходимости внести коррективы.

Виды токсических изменений нейтрофилов
Для оценки степени токсических изменений нейтрофилов используется специальная классификация. Врачи разработали систему, основанную на так называемых «плюсах». Эта система позволяет оценить размер гранул, образовавшихся в пораженных клетках, а также процентное содержание этих клеток:
- Токсическая зернистость «плюс» — выявляется мелкая, «пылеобразная» зернистость.
- Диагноз «два плюса» ставится, если зернистость имеет средний размер, а количество аномальных клеток составляет примерно 50%.
- Зернистость «три плюса» — в клетках наблюдаются крупные измененные гранулы, при этом поражение клеток достигает 75%.
- Если анализ показывает «четыре плюса», это свидетельствует о наличии серьезного угрожающего заболевания крови, при котором в клетках имеются крупные гранулы, а цитоплазма становится разреженной.
Также выделяют следующие типы изменений:
- Собственно зернистость.
- Структуры Деле, которые имеют изменчивые размеры и формы, окрашенные в светло-синий цвет.
- Вакуолизация — образование вакуолей в клеточной плазме. Это может происходить при серьезных заболеваниях, таких как сепсис, или при лейкоцитозе. Вакуолизация может сочетаться с элементами Деле и другими патологиями.
- Гиперсегментация — наличие более пяти сегментов в ядре клеток. Это состояние наблюдается при мегалобластной анемии и редко встречается у здоровых людей как особая наследственная черта.
Обнаружение патогенной зернистости
Для выявления данного нарушения используются Фуксин и метиленовый синий. Приготовление раствора Фуксина осуществляется следующим образом:
- В 15 г 96-процентного этанола растворяется 1 грамм красителя, для чего применяется нагревание.
- Затем в полученный раствор добавляется 100 граммов 5-процентного раствора карболовой кислоты.
- После этого в 20 мл воды вводится 7 капель полученного раствора, а также 5 капель 1-процентного метиленового синего. Смесь тщательно перемешивается. Далее ею окрашивают мазки в течение одного часа, после чего их смывают и сушат. В результате можно наблюдать зернистость (пыль, хлопья).
Последствия изменений
Что означает превышение нормальных показателей токсической зернистости? Это явление указывает на реакцию организма на воспалительный процесс.
В большинстве случаев токсигенная зернистость является признаком нейтрофилии, то есть увеличения числа нейтрофилов в крови. Также это может указывать на сдвиг лейкоцитарной формулы влево.
Если наблюдается рост процента деградировавших нейтрофилов, это может свидетельствовать о развитии бактериемии и генерализации инфекционного процесса. Когда же количество патологически измененных нейтрофилов превышает 50% при гнойных или септических состояниях, или этот показатель продолжает расти, это становится неблагоприятным прогностическим знаком.
Врач учитывает динамику изменений токсической зернистости и при необходимости корректирует лечение. Резкое увеличение процента измененных нейтрофилов является тревожным сигналом.
Вопрос-ответ
Когда появляется токсическая зернистость нейтрофилов?
Грубая зернистость нейтрофилов называется токсической зернистостью. Она появляется в результате поглощения нейтрофилами токсичных веществ. Является реакцией клеток крови на инфекцию в организме и маркером тяжести гнойно-септических заболеваний.
Что означают нейтрофилы с токсической зернистостью?
Токсичные гранулы указывают на сокращение времени созревания и активацию постмитотического пула нейтрофилов. Они обнаруживаются при инфекциях и острых воспалениях и часто связаны с тельцами включения Доула.
Что такое токсическая грануляция нейтрофилов?
Токсическая зернистость (грануляция). Под токсической зернистостью принято понимать появление мелких красных зерен (гранул) в цитоплазме нейтрофилов. Данный вид нейтрофильной токсичности характерен для лошадей, коров, лам, верблюдов. Он редко встречается у собак и кошек.
Что такое ТЗН в анализе крови?
Токсическая зернистость нейтрофилов, качественно. Лейкоциты – основной тип клеток крови. Они вовлечены в функционирование иммунной системы. Их роль проявляется в процессах воспаления, при аллергиях, а также в противоопухолевой защите.
Советы
СОВЕТ №1
Изучите основные причины токсической зернистости нейтрофилов. Это может помочь вам лучше понять, какие заболевания или состояния могут быть связаны с изменениями в анализах крови. Обратите внимание на инфекции, воспалительные процессы и другие медицинские состояния.
СОВЕТ №2
Обсудите результаты анализов с вашим врачом. Если у вас обнаружена токсическая зернистость нейтрофилов, важно получить профессиональную интерпретацию результатов и рекомендации по дальнейшим действиям. Не стесняйтесь задавать вопросы о возможных причинах и лечении.
СОВЕТ №3
Следите за своим здоровьем и обращайте внимание на симптомы, которые могут указывать на инфекции или воспаления. Раннее выявление и лечение заболеваний могут помочь предотвратить развитие серьезных осложнений и улучшить общее состояние здоровья.
СОВЕТ №4
Поддерживайте здоровый образ жизни, включая сбалансированное питание, регулярные физические нагрузки и достаточный сон. Это поможет укрепить иммунную систему и снизить риск инфекций, которые могут привести к изменениям в составе крови.